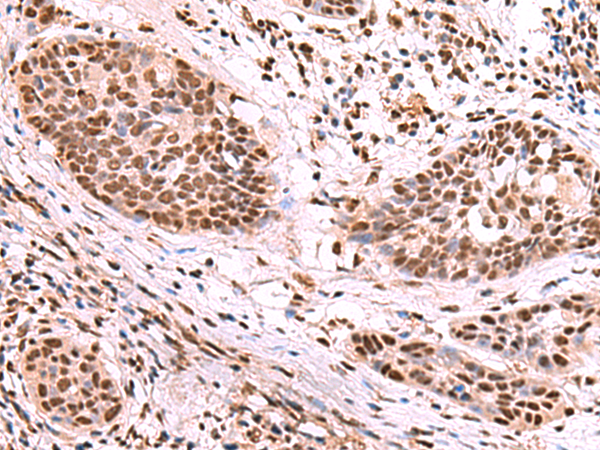

中文名稱: 兔抗SF3B3多克隆抗體
英文名稱: Anti-SF3B3 rabbit polyclonal antibody
別 名: splicing factor 3b subunit 3; RSE1; SAP130; SF3b130; STAF130
相關(guān)類別: 一抗
儲(chǔ) 存: 冷凍(-20℃)
宿 主: Rabbit
抗 原: SF3B3
反應(yīng)種屬: Human, Mouse
標(biāo) 記 物: Unconjugate
克隆類型: rabbit polyclonal
技術(shù)規(guī)格
|
Background: |
This gene encodes subunit 3 of the splicing factor 3b protein complex. Splicing factor 3b, together with splicing factor 3a and a 12S RNA unit, forms the U2 small nuclear ribonucleoproteins complex (U2 snRNP). The splicing factor 3b/3a complex binds pre-mRNA upstream of the intron's branch site in a sequence independent manner and may anchor the U2 snRNP to the pre-mRNA. Splicing factor 3b is also a component of the minor U12-type spliceosome. Subunit 3 has also been identified as a component of the STAGA (SPT3-TAF(II)31-GCN5L acetylase) transcription coactivator-HAT (histone acetyltransferase) complex, and the TFTC (TATA-binding-protein-free TAF(II)-containing complex). These complexes may function in chromatin modification, transcription, splicing, and DNA repair. |
|
Applications: |
ELISA, IHC |
|
Name of antibody: |
SF3B3 |
|
Immunogen: |
Fusion protein of human SF3B3 |
|
Full name: |
splicing factor 3b subunit 3 |
|
Synonyms: |
RSE1; SAP130; SF3b130; STAF130 |
|
SwissProt: |
Q15393 |
|
ELISA Recommended dilution: |
5000-10000 |
|
IHC positive control: |
Human esophagus cancer and Human thyroid cancer |
|
IHC Recommend dilution: |
50-300 |
購物車
幫助
021-54845833/15800441009
